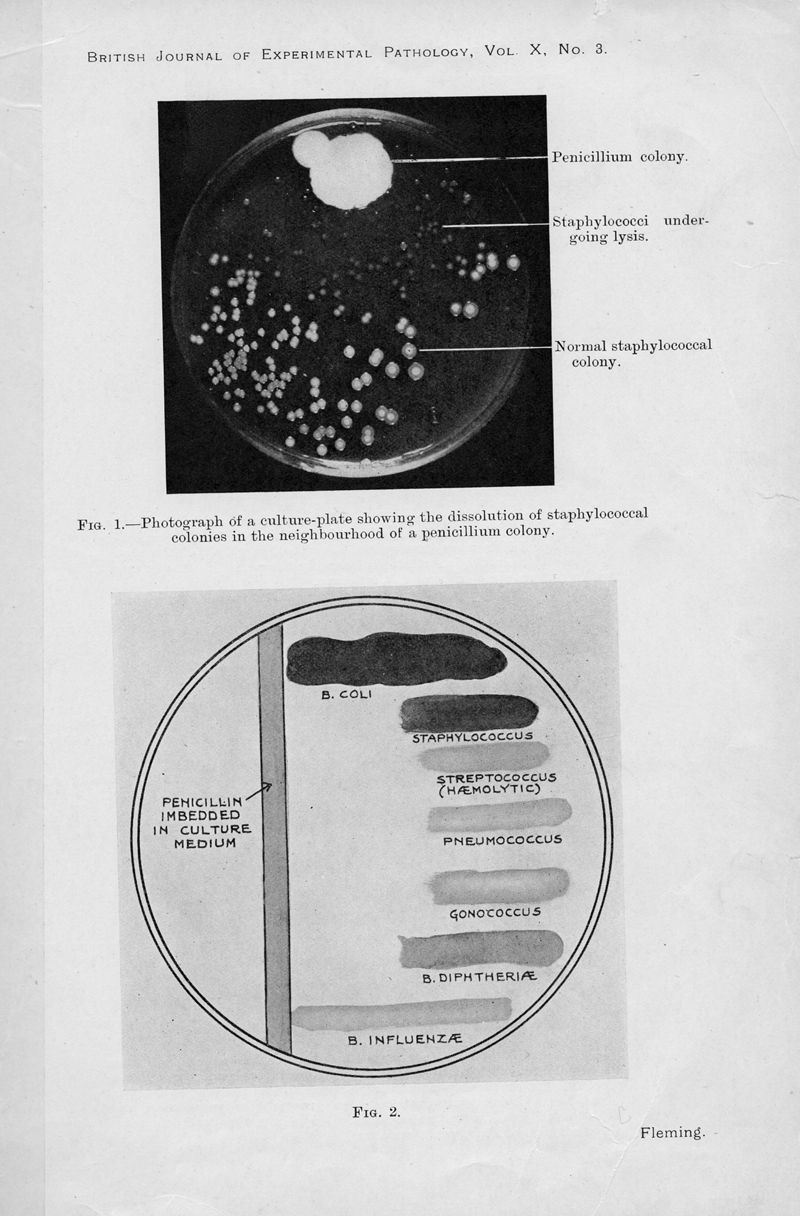

Présentation • Mode d’emploi • Services associés • Réutilisations
|
In : [The] British journal of experimental pathology,
1929, vol. 10, pp. 226-236
|
|
|
|
In : [The] British journal of experimental pathology,
1929, vol. 10, pp. 226-236
|